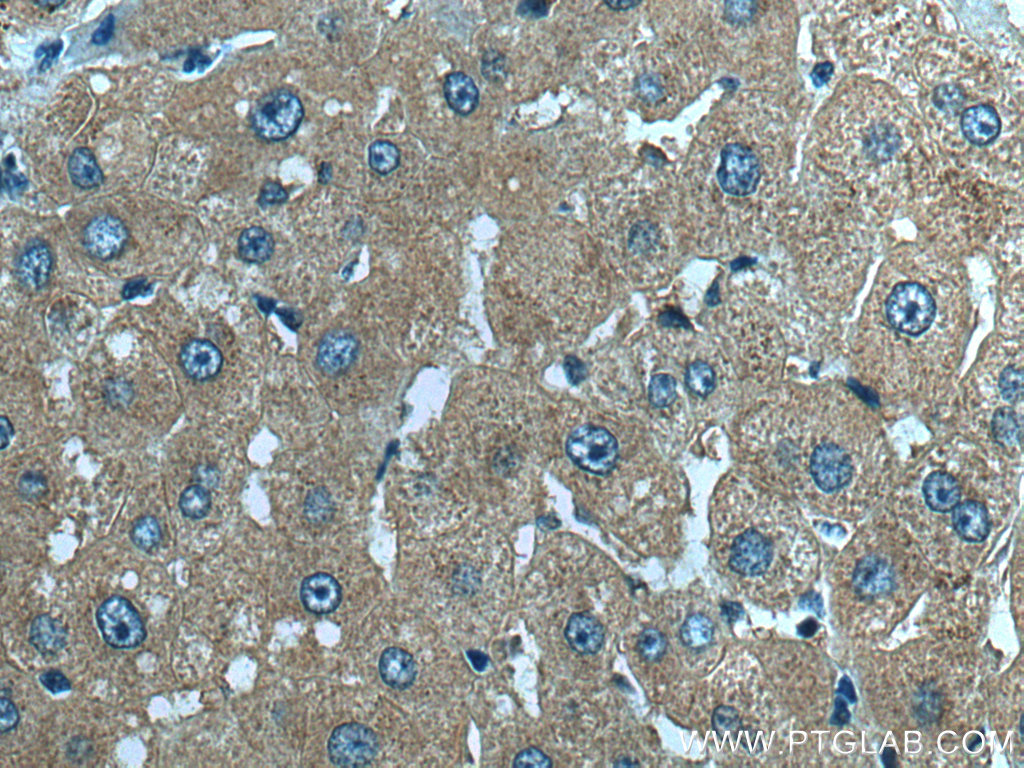

验证数据展示
经过测试的应用
| Positive WB detected in | HeLa cells, A549 cells, Jurkat cells, and mouse liver tissue |
| Positive IHC detected in | mouse brain tissue, human liver tissue, human lung cancer tissue Note: suggested antigen retrieval with TE buffer pH 9.0; (*) Alternatively, antigen retrieval may be performed with citrate buffer pH 6.0 |
| Positive IF/ICC detected in | MCF-7 cells |
推荐稀释比
| 应用 | 推荐稀释比 |
|---|---|
| Western Blot (WB) | WB : 1:1000-1:6000 |
| Immunohistochemistry (IHC) | IHC : 1:50-1:500 |
| Immunofluorescence (IF)/ICC | IF/ICC : 1:50-1:500 |
| It is recommended that this reagent should be titrated in each testing system to obtain optimal results. | |
| Sample-dependent, Check data in validation data gallery. | |
产品信息
51045-1-AP targets Snf1lk in WB, IHC, IF/ICC, ELISA applications and shows reactivity with human, mouse samples.
| 经测试应用 | WB, IHC, IF/ICC, ELISA Application Description |
| 文献引用应用 | WB, IHC, IF |
| 经测试反应性 | human, mouse |
| 文献引用反应性 | human, mouse, rat |
| 免疫原 |
CatNo: Ag3913 Product name: Recombinant mouse Snf1lk protein Source: e coli.-derived, PGEX-4T Tag: GST Domain: 423-769 aa of NM_010831 Sequence: LDTNCSGVFRHRSISPSSLLDTAISEEARQGPSLEEEQEVQEPLPGSTGRRHTLAEVSTHFSPLNPPCIIVSSSATASPSEGTSSDSCLPFSASEGPAGLGSGLATPGLLGTSSPVRLASPFLGSQSATPVLQTQAGLGTAVLPPVSFQEGRRASDTSLTQGLKAFRQQLRKNARTKGFLGLNKIKGLARQVCQSSVRTPRGGMSTFHTPAPSSGLQGCTTSNREGRSLLEEVLHQQRLLQLQHHSSTAAASSGCQQGPQLSPVPYVLAPCDSLLVSGIPLLPTPLLQAGMSPVASAAHLLDTHLHISAGPVALPTGPLPQCLTRLSPGCDPAGLPQGDCEMEDLTS 种属同源性预测 |
| 宿主/亚型 | Rabbit / IgG |
| 抗体类别 | Polyclonal |
| 产品类型 | Antibody |
| 全称 | salt inducible kinase 1 |
| 别名 | Sik1, EC:2.7.11.1, HRT-20, Msk, Myocardial SNF1-like kinase |
| 计算分子量 | 85 kDa |
| 观测分子量 | 85-100 kDa |
| GenBank蛋白编号 | NM_010831 |
| 基因名称 | Sik1 |
| Gene ID (NCBI) | 17691 |
| RRID | AB_2187322 |
| 偶联类型 | Unconjugated |
| 形式 | Liquid |
| 纯化方式 | Antigen affinity purification |
| UNIPROT ID | Q60670 |
| 储存缓冲液 | PBS with 0.02% sodium azide and 50% glycerol, pH 7.3. |
| 储存条件 | Store at -20°C. Stable for one year after shipment. Aliquoting is unnecessary for -20oC storage. |
背景介绍
SIK1(Salt-inducible kinase 1) is also named SIK, SNF1LK, and belongs to the CAMK Ser/Thr protein kinase family. It associates constitutively with the NK regulatory complex and is responsible for increases in its catalytic activity following small elevations in intracellular sodium concentrations(PMID:17939993). SIK1 is required for the phosphorylation of class II HDACs and the expression of MEF2 target genes in myocytes(PMID:17468767). Defects in SIK1 may be associated with some cancers, such as breast cancer. Loss of SIK1 correlates with poor patient outcomes in breast cancers(PMID:19622832). SIK1 also can be detected 95-100 kDa (PMID: 26567857, PMID: 22109884).
实验方案
| Product Specific Protocols | |
|---|---|
| IF protocol for Snf1lk antibody 51045-1-AP | Download protocol |
| IHC protocol for Snf1lk antibody 51045-1-AP | Download protocol |
| WB protocol for Snf1lk antibody 51045-1-AP | Download protocol |
| Standard Protocols | |
|---|---|
| Click here to view our Standard Protocols |
发表文章
| Species | Application | Title |
|---|---|---|
Phytomedicine Wen-Shen-Jian-Pi-Hua-Tan decoction protects against early obesity-related glomerulopathy by improving renal bile acid composition and suppressing lipogenesis, inflammation, and fibrosis | ||
iScience Demethylase FTO-mediated m6A modification of SIK1 modulates placental cytotrophoblast syncytialization in type 2 diabetes mellitus
| ||
J Neuroinflammation High-salt diet downregulates TREM2 expression and blunts efferocytosis of macrophages after acute ischemic stroke. | ||
J Cell Physiol ETNPPL modulates hyperinsulinemia-induced insulin resistance through the SIK1/ROS-mediated inactivation of the PI3K/AKT signaling pathway in hepatocytes | ||
J Cereb Blood Flow Metab Role of salt-induced kinase 1 in androgen neuroprotection against cerebral ischemia. | ||
J Leukoc Biol SIK inhibition in human myeloid cells modulates TLR and IL-1R signaling and induces an anti-inflammatory phenotype. |